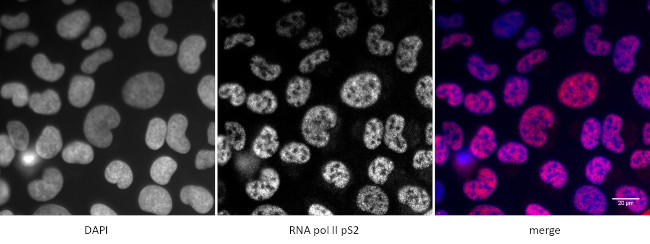
Phospho-RNA pol II CTD (Ser2) Antibody in Immunocytochemistry (ICC/IF)

Search
Active Motif
Phospho-RNA pol II CTD (Ser2) Monoclonal Antibody (3E10)
{{$productOrderCtrl.translations['antibody.pdp.commerceCard.promotion.promotions']}}
{{$productOrderCtrl.translations['antibody.pdp.commerceCard.promotion.viewpromo']}}
{{$productOrderCtrl.translations['antibody.pdp.commerceCard.promotion.promocode']}}: {{promo.promoCode}} {{promo.promoTitle}} {{promo.promoDescription}}. {{$productOrderCtrl.translations['antibody.pdp.commerceCard.promotion.learnmore']}}
产品信息
61083
种属反应
已发表种属
宿主/亚型
分类
类型
克隆号
抗原
偶联物
形式
浓度
规格
纯化类型
保存液
内含物
保存条件
运输条件
RRID
靶标信息
RNA polymerase II is the enzyme responsible for the synthesis of mRNA and many non-coding RNAs. POLR2A encodes RNA polymerase II subunit B1 (RPB1), the largest subunit of RNA polymerase II. The C-terminal domain (CTD) of RPB1 contains tandem heptapeptide repeats with the consensus sequence YSPTSPS. Phosphorylation and other modifications within this sequence influence the recruitment of factors that regulate the transcription cycle. Recruitment of RNA processing factors to the elongation complex is coordinated by the phosphorylation of Serine-2 and Serine-5 residues within the CTD.
仅用于科研。不用于诊断过程。未经明确授权不得转售。
生物信息学
蛋白别名: 3'-5' exoribonuclease; DNA-directed RNA polymerase II largest subunit, RNA polymerase II 220 kd subunit; DNA-directed RNA polymerase II subunit A; DNA-directed RNA polymerase II subunit RPB1; DNA-directed RNA polymerase III largest subunit; EC 2.7.7.6; MGC75453; Pol II S2p; polymerase (RNA) II (DNA directed) polypeptide A, 220kDa; polymerase (RNA) II subunit A; POLYMERASE II; RNA; RNA POL2; RNA polymerase II; RNA polymerase II 1; RNA polymerase II C-terminal domain; RNA polymerase II carboxy-terminal domain; RNA polymerase II subunit B1; RNA-directed RNA polymerase II subunit RPB1; RP02; RPB220; RPO21; SUA8; unnamed protein product
基因别名: 220kDa; hRPB220; hsRPB1; NEDHIB; POLR2; POLR2A; POLRA; RPB1; RPBh1; Rpii215; RpIILS; RPO2; Rpo2-1; RPOL2
UniProt ID: (Human) P24928, (Mouse) P08775
Entrez Gene ID: (Human) 5430, (Mouse) 20020